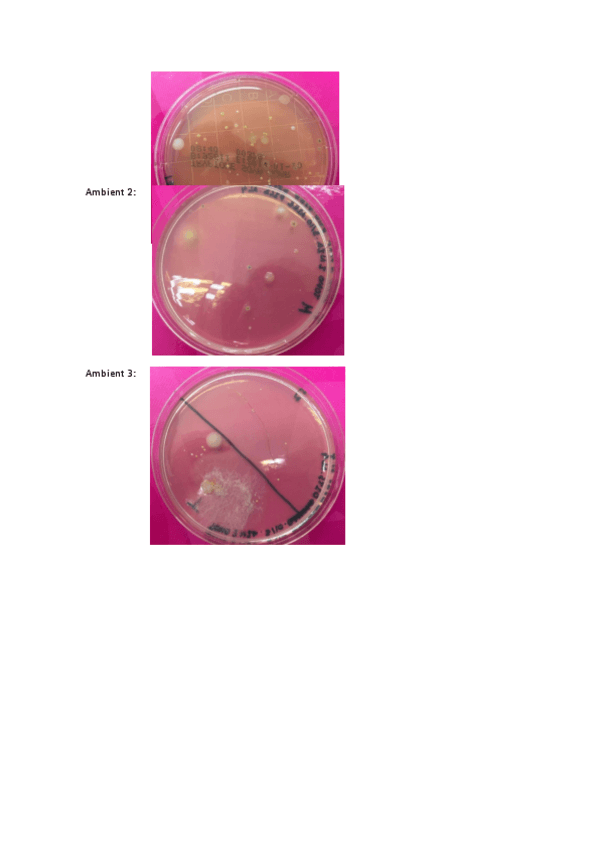

@Estefania_Llorens
78 Publicaciones
3.27k Interacciones
0 Seguidores
0 Siguiendo
Lista de publicaciones de Estefania_Llorens
He publicado nuevos apuntes de 3º Gestión y Conservación de Suelos y Aguas: Gestio-i-Conservacio-Sols-i-Aigues-20-21-Estefania-Llorens.pdf
He publicado nuevos apuntes de 3º Gestión y Conservación de Suelos y Aguas: Bloc-I.pdf
He publicado nuevos apuntes de 3º Evaluación de Impacto Ambiental: PREGUNTAS-TEST-EIA.pdf
He publicado nuevos apuntes de 3º Tecnologías Para el Control de la Contaminación: PREGUNTAS-EXAMEN-TEST-TCC-2o-CONV--TESTS-AVALUACIO-CONTINUA.pdf
He publicado nuevos apuntes de 2º Edafología: EXAMEN-TEST-EDAFOLOGIA-JUAN-SANCHEZ.pdf
He publicado nuevos apuntes de 3º Tecnologías Para el Control de la Contaminación: Examen-TCC.pdf
He publicado nuevos apuntes de 3º Sistemas Integrados de Gestión: Apunts-sistemes-integrats-de-gestio.pdf
He publicado nuevos apuntes de 3º Evaluación de Impacto Ambiental: AVALUACIO-DIMPACTE-AMBIENTAL.pdf
He publicado nuevos apuntes de 2º Geografía Física: GEOGRAFIA-FISICA.pdf
He publicado nuevos apuntes de 2º Geografía Física: QUADERN-DE-PRACTIQUES.pdf
He publicado nuevos apuntes de 3º Ordenación del Territorio: ORDENACIO-DE-TERRITORI-temari-19-20-complet.pdf
He publicado nuevos apuntes de 3º Tecnologías Para el Control de la Contaminación: APUNTS-TCC.pdf
He publicado nuevos apuntes de 3º Tecnologías Para el Control de la Contaminación: APUNTS-BOLC-II-TCC.pdf
He publicado nuevos apuntes de 3º Tecnologías Para el Control de la Contaminación: BLOC-I-Estefania-Llorens.pdf
He publicado nuevos apuntes de 3º Economía y Medio Ambiente: APUNTS-ECONOMIA-2019-2020.pdf
He publicado nuevos trabajos de 3º Economía y Medio Ambiente: Fenomen-NIMBY-Estefania-Llorens-Silvestre.pdf
He publicado nuevos apuntes de 2º Microbiología Ambiental: QUESTIONS-DE-PRACTIQUES-17.pdf
He publicado nuevos apuntes de 1º Sociedad, Población y Territorio: Apunts-SPT-2018.pdf